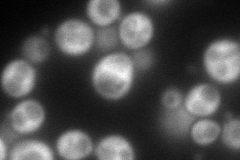
YBL091C
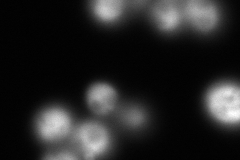
YBL091C
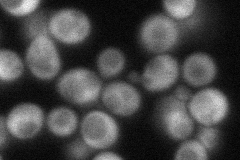
YBL091C
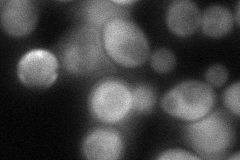
YBL091C
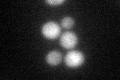
YBL091C
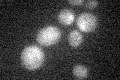
YBL091C

View description
Methionine aminopeptidase, catalyzes the cotranslational removal of N-terminal methionine from nascent polypeptides; function is partially redundant with that of Map1p
Localization:
Intensity:
Fold change:
Significance:
-
C’ GFP library in SD

nucleus31.97 -
N' NOP1pr-GFP in SD
cytosol208.185 -
N' TEF2pr-mCherry in SD
ambiguous,cytosol264.439 -
N' NATIVEpr-GFP in SD
cytosol56.5725 -
N' TEF2pr-VC and Cyto-VN in SD
cytosol73.2284 -
C’ GFP library in SD+DTT
nucleus29.310.91No -
C’ GFP library in SD+H2O2

nucleus30.130.94No -
C’ GFP library in Starvation Media
nucleus17.110.53Yes -
C’ GFP library on the background of Pup2-DaMP

nucleus -
C’ GFP library on the background of CCT mutant

nucleus28.3930.887901No
